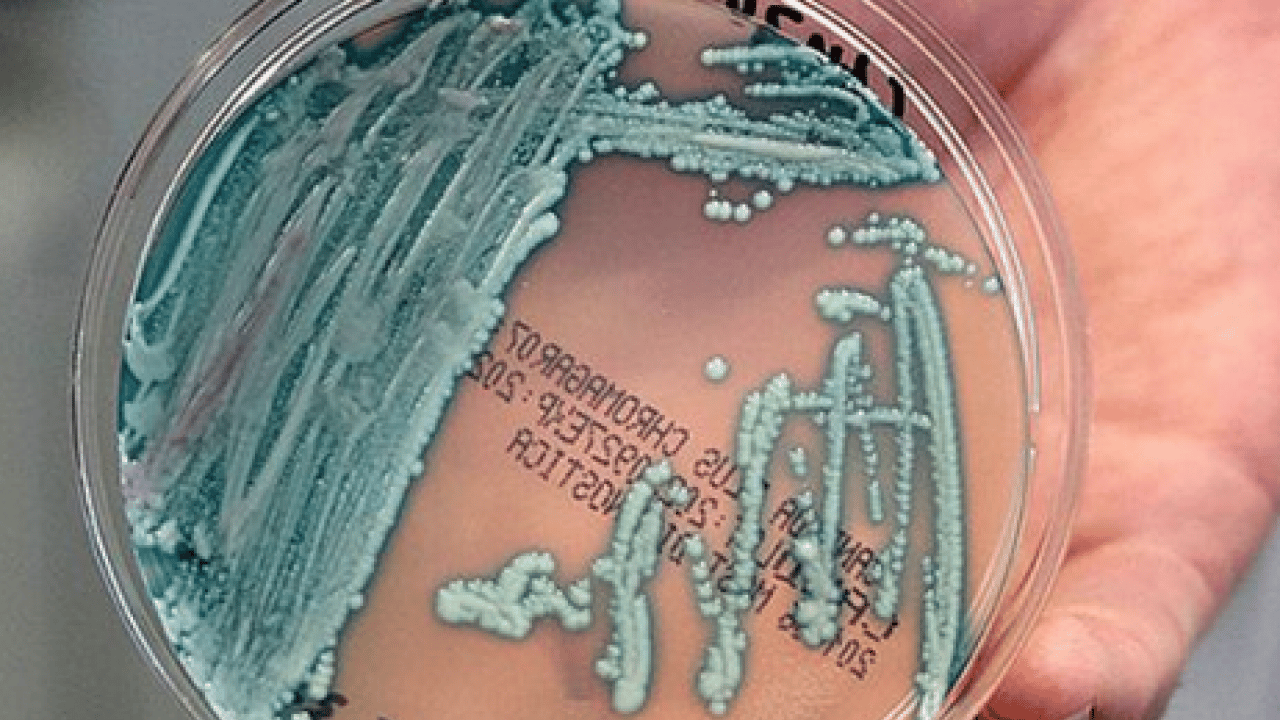
Foto - Candidozyma auris adlı mantara karşı ciddi çalışma! Mantarların çoğalma ve iletişim mekanizmaları...
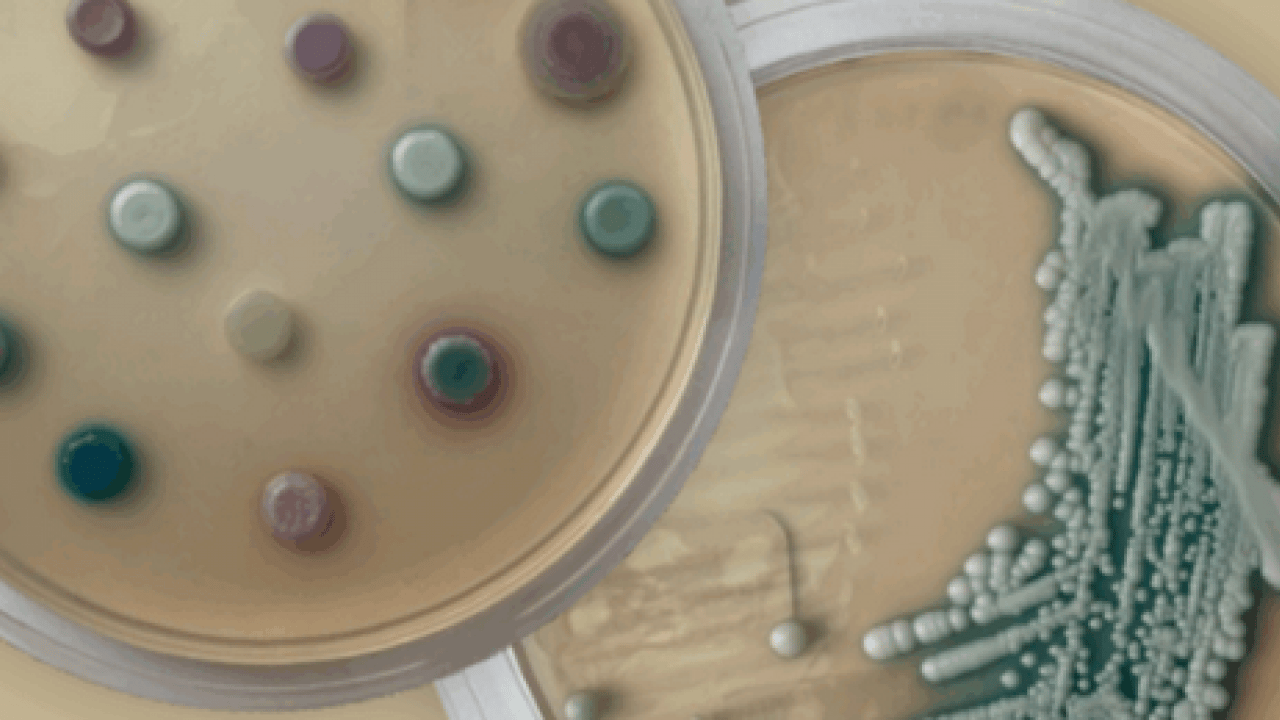
Foto - Candidozyma auris adlı mantara karşı ciddi çalışma! Mantarların çoğalma ve iletişim mekanizmaları...
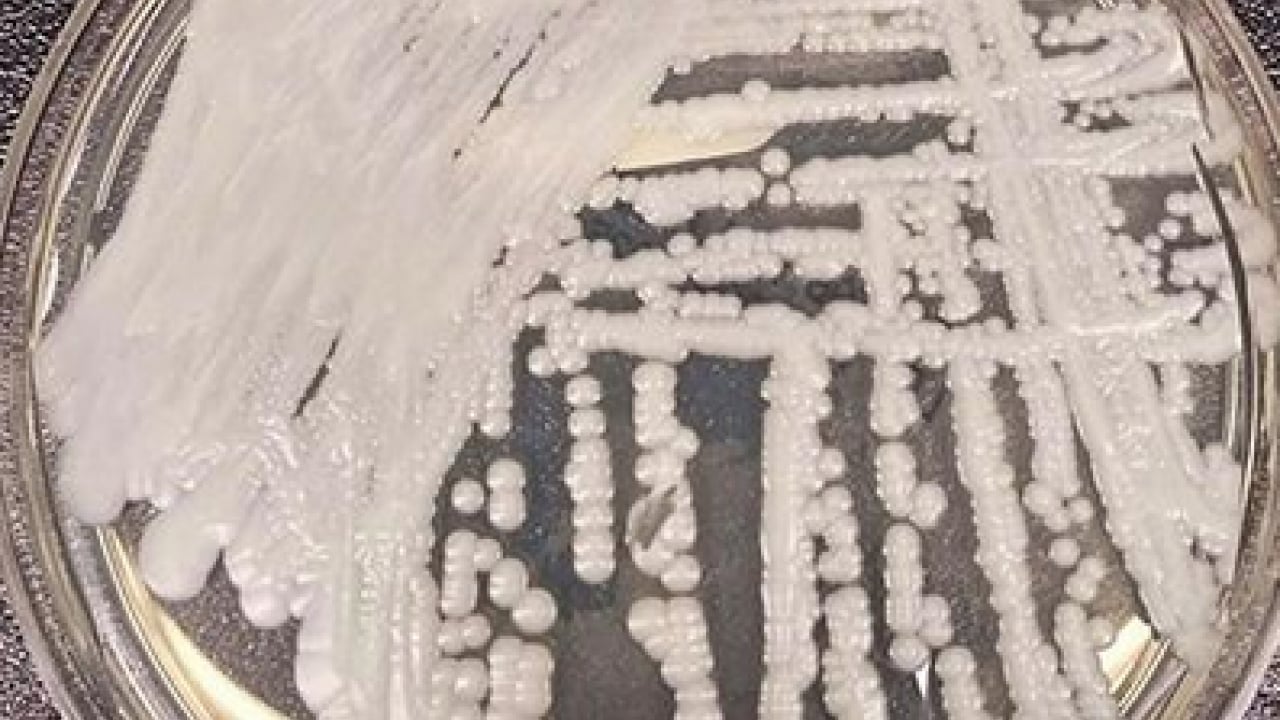
Foto - Candidozyma auris adlı mantara karşı ciddi çalışma! Mantarların çoğalma ve iletişim mekanizmaları...
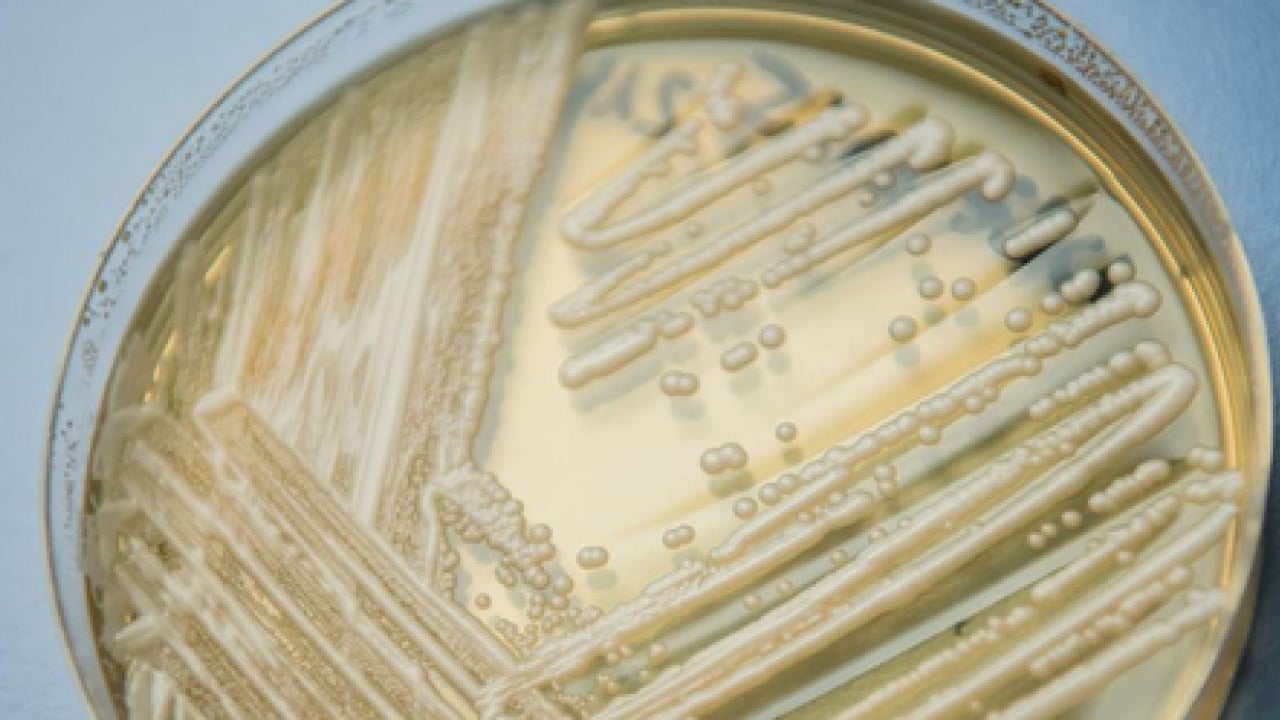
Foto - Candidozyma auris adlı mantara karşı ciddi çalışma! Mantarların çoğalma ve iletişim mekanizmaları...
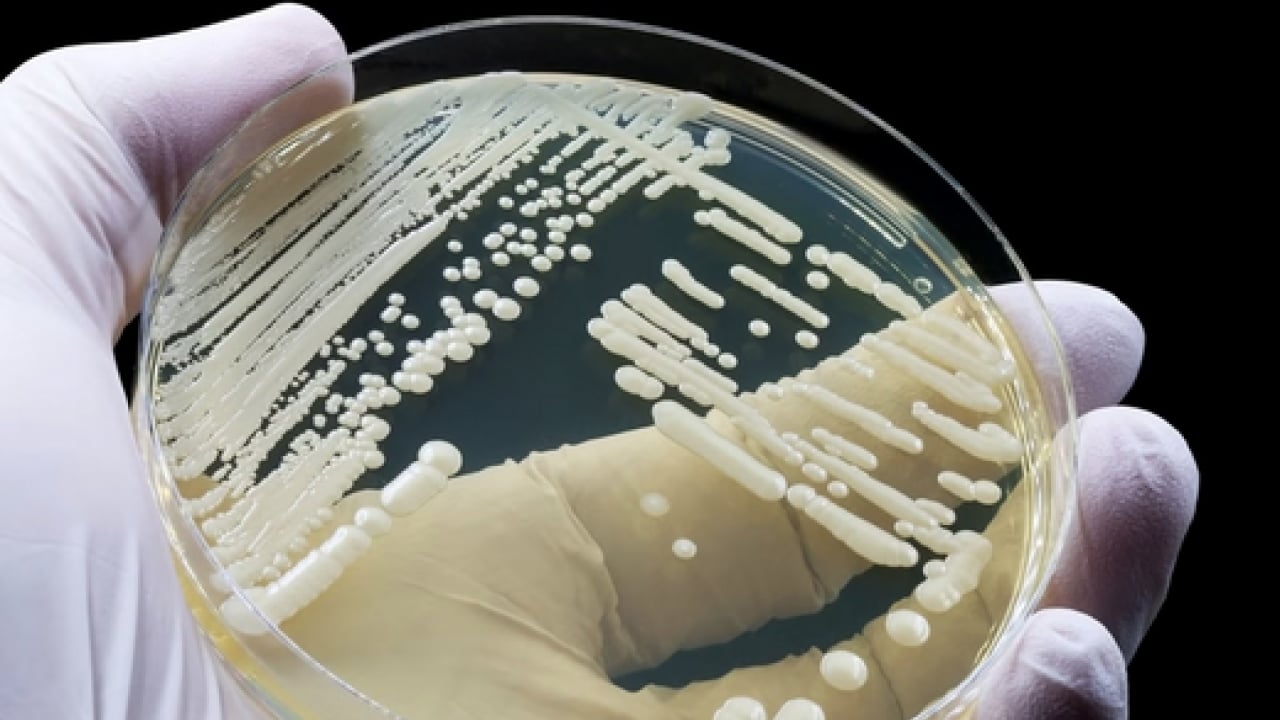
Foto - Candidozyma auris adlı mantara karşı ciddi çalışma! Mantarların çoğalma ve iletişim mekanizmaları...

Candidozyma auris adlı mantara karşı ciddi çalışma! Mantarların çoğalma ve iletişim mekanizmaları...
Uzman isim bu mantara karşı oluşan enfeksiyona karşı tüm detayları tek tek açıkladı.
Uzman isim bu mantara karşı oluşan enfeksiyona karşı tüm detayları tek tek açıkladı.
Biruni Üniversitesi Tıp Fakültesi Tıbbi Mikrobiyoloji Ana Bilim Dalı öğretim üyesi Dr. Yağmur Ekenoğlu Merdan, yürütücülüğünü üstlendiği projede, son yıllarda hastanelerde daha sık görülen ve tedavisi zorlaşan "candidozyma auris" adlı mantara karşı yeni bir tedavi yaklaşımının araştırıldığını söyledi.
TÜBİTAK-ARDEB 1002-A Hızlı Destek Modülü kapsamında desteklenmeye değer bulunan çalışmada, mevcut mantar ilaçlarının etkinliğini artırmaya yönelik yenilikçi bir yöntem laboratuvar ortamında inceleniyor.
Projede ele alınan candidozyma auris'in, özellikle bağışıklık sistemi zayıf hastalarda ciddi enfeksiyonlara yol açabildiğini belirten Dr. Ekenoğlu Merdan, bu mantar türünün birçok yaygın ilaca karşı direnç geliştirebildiğine dikkat çekti. Dr. Ekenoğlu Merdan, "Hastane enfeksiyonları açısından önemli bir sorun haline gelen candidozyma auris, mevcut tedavilere her zaman yeterli yanıt vermeyebiliyor. Bu da yeni ve destekleyici tedavi yaklaşımlarını gerekli kılıyor" dedi.
Araştırma hakkında bilgi veren Dr. Ekenoğlu Merdan, "Mantarların çoğalma ve iletişim mekanizmalarını baskılayabilen farnesol adlı bir maddenin, özel taşıyıcı yapılarla birlikte kullanılması ve yaygın olarak kullanılan flukonazol adlı mantar ilacıyla oluşturduğu birlikte etkinin değerlendirilmesini hedefliyoruz.
Bu yaklaşımın, ilacın mantar üzerindeki etkisini artırarak daha etkili ve güvenli tedavi seçeneklerine katkı sağlayabileceğini öngörüyoruz" dedi.
baskıladığı ve tedaviye katkı potansiyeli laboratuvar ortamında test edildiğini söyleyen Dr. Ekenoğlu Merdan, "Amacımız mevcut antifungal ilaçların etkinliğini artırabilecek, uygulanabilir ve güvenli yeni yaklaşımlar ortaya koymak.
Bu tür çalışmalar, dirençli enfeksiyonlarla mücadelede önemli bir bilimsel zemin oluşturuyor" diye konuştu.
Gelecek çalışmalara bilimsel altyapı sunması bekleniyor
Araştırmadan elde edilecek bulguların, dirençli mantar enfeksiyonlarına yönelik yeni tedavi stratejilerinin geliştirilmesine katkı sağlaması ve ileride yapılacak daha kapsamlı çalışmalara yol göstermesi amaçlanıyor.
WhatsApp İhbar Hattı
+90 (553) 313 94 23